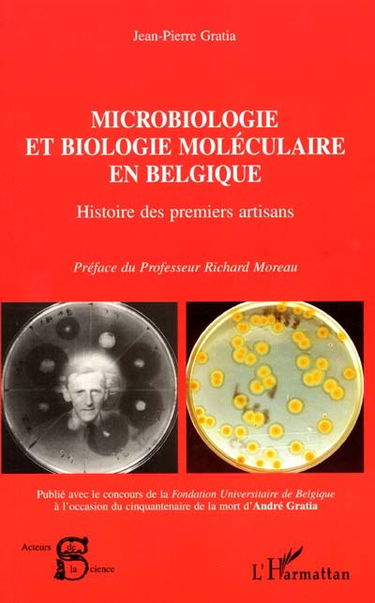
Microbiologie et biologie moléculaire en Belgique : histoire des premiers artisans

Livres d’occasion sur les Sciences, Techniques et la Médecine
Le monde dans lequel nous vivons devient de plus en plus technique et les savoir-faire sont très préconisés. Que ce soit pour un but professionnel ou juste par curiosité, les livres en sciences, techniques et médecine peuvent donner un point de vue plus précis et fiable qu’internet et sont donc vivement recommandés pour tout lecteur qui veut développer ses connaissances dans ces sujets. Agriculture, mathématiques, sciences de la vie, sciences de la terre, histoire des sciences, astronomie, bâtiment, médecine ou encore sciences pour tous : nous vous proposons de découvrir notre sélection de livres d’occasion en sciences, techniques et médecine à petit prix. Lire la suite En voir moins
Affiner la sélection : Médecine, Sciences pour tous, Agriculture - Agroalimentaire, Mathématiques, Sciences de la vie - Biologie - Génétique, Sciences de la terre - Eau - Environnement, Histoire des sciences, Astronomie, Bâtiment - Travaux publics - Matériaux, Personnages scientifiques, Physique - Sciences de la matière, Techniques industrielles, Chimie, Sciences vétérinaires, Artisanat, Chaos